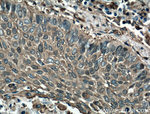
Cofilin Antibody in Immunohistochemistry (Paraffin) (IHC (P))
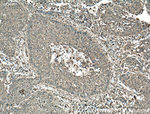
Cofilin Antibody in Immunohistochemistry (Paraffin) (IHC (P))
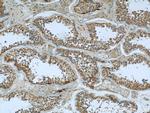
Cofilin Antibody in Immunohistochemistry (Paraffin) (IHC (P))

Search
Proteintech
Cofilin Monoclonal Antibody (1G6A2)
{{$productOrderCtrl.translations['antibody.pdp.commerceCard.promotion.promotions']}}
{{$productOrderCtrl.translations['antibody.pdp.commerceCard.promotion.viewpromo']}}
{{$productOrderCtrl.translations['antibody.pdp.commerceCard.promotion.promocode']}}: {{promo.promoCode}} {{promo.promoTitle}} {{promo.promoDescription}}. {{$productOrderCtrl.translations['antibody.pdp.commerceCard.promotion.learnmore']}}
产品信息
66057-1-IG
种属反应
已发表种属
宿主/亚型
分类
类型
克隆号
抗原
偶联物
形式
浓度
规格
纯化类型
保存液
内含物
保存条件
运输条件
产品详细信息
Immunogen sequence: MASGVAVSD GVIKVFNDMK VRKSSTPEEV KKRKKAVLFC LSEDKKNIIL EEGKEILVGD VGQTVDDPYA TFVKMLPDKD CRYALYDATY ETKESKKEDL VFIFWAPESA PLKSKMIYAS SKDAIKKKLT GIKHELQANC YEEVKDRCTL AEKLGGSAVI SLEGKPL (1-166 aa encoded by BC012318)
靶标信息
Cofilin binds to F-actin and exhibits pH-sensitive F-actin depolymerizing activity. Regulates actin cytoskeleton dynamics. Important for normal progress through mitosis and normal cytokinesis. Plays a role in the regulation of cell morphology and cytoskeletal organization. Required for the up-regulation of atypical chemokine receptor ACKR2 from endosomal compartment to cell membrane, increasing its efficiency in chemokine uptake and degradation. Required for neural tube morphogenesis and neural crest cell migration.
仅用于科研。不用于诊断过程。未经明确授权不得转售。
生物信息学
蛋白别名: 18 kDa phosphoprotein; CFL-1; COF1; cofilin; cofilin 1 (non-muscle); Cofilin, non-muscle isoform; Cofilin-1; Cofilin1; epididymis secretory protein Li 15; p18; unnamed protein product
基因别名: AA959946; CFL; CFL1; Cof; COFILIN; HEL-S-15; n-cofilin
UniProt ID: (Human) P23528, (Pig) P10668, (Rat) P45592, (Mouse) P18760
Entrez Gene ID: (Rabbit) 100341589, (Human) 1072, (Pig) 445532, (Rat) 29271, (Mouse) 12631